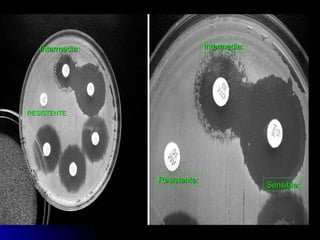
COORDINACION PRACTICA 2006-2007COORDINACION PRACTICA 2006-2007 2222
Resistente:Resistente:
Sensible:Sensible:
Intermedia:Intermedia:Intermedia:Intermedia:
Sensible:Sensible:
RESISTENTERESISTENTE
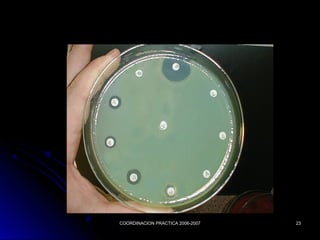
COORDINACION PRACTICA 2006-2007COORDINACION PRACTICA 2006-2007 2323
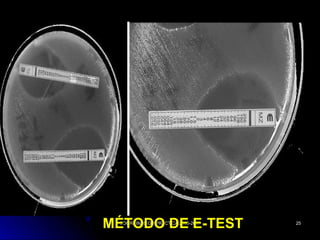
COORDINACION PRACTICA 2006-2007COORDINACION PRACTICA 2006-2007 2525
MÉTODO DE E-TESTMÉTODO DE E-TEST

El documento describe los antibiogramas o antibioticogramas, que estudian la sensibilidad de los microorganismos a los antibióticos mediante métodos de laboratorio. Explica que un antibiograma consiste en poner en contacto al germen aislado con distintos antibióticos para determinar cuál es el más efectivo para el tratamiento. Además, detalla los objetivos y requisitos de un antibiograma, así como los diferentes tipos de pruebas que se pueden realizar, como la dilución y la difusión.